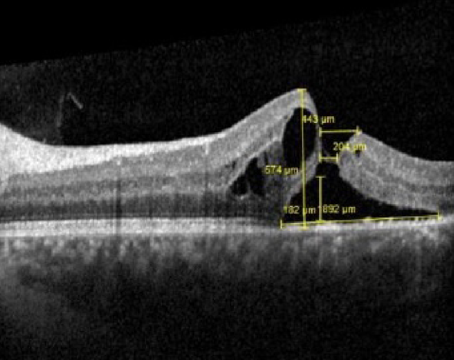

November / December 2024
Features

Emerging treatments for non-infectious uveitis
A look at the most interesting treatments in the pharmaceutical pipeline.
How to recognize predictors of spontaneous macular hole closure
A review of anatomical characteristics of holes more likely to close without surgery and noninterventional management options.

Novel advances and emerging therapies for RVO
A review of the data on various approaches for treating retinal vein occlusion.
Departments
Editor's Page
Imaging Forum
Morning Glory Syndrome
Imaging is key to correctly diagnosing this optic disc anomaly.
North of the Border
Global burden of non-infectious uveitis
What do recent studies tell us about the impact of uveitis on patients?
Retina Rounds
More than meets the macula
When it’s not so easy to differentiate pentosan polysulfate toxicity from age-related macular degeneration.
Social Media Specialist
Home is where the heart is, but ...
... it can also be where shared pain and understanding are in the form of a social media community.
Surgical Pearl Video
A novel approach to MH-RD in an infant
Tenon’s capsule and amniotic membrane grafts to manage a rare bilateral macular hole-related retinal detachment.



